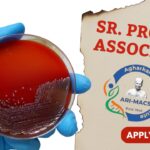
Sr. Project Associate Job at MACS ARI Pune – Apply Now

Home Search
bioinformatics - search results
If you're not happy with the results, please do another search
MACS ARI Pune as Sr. Project Associate in the Bioenergy Field – Apply Now!
Sr. Project Associate Job at MACS ARI Pune – Apply Now
MACS ARI Pune, a premier research institute in bioenergy, is inviting applications for the...
Associate Director Job Eli Lilly – R&D Informatics Data Capability, Apply Now!
Associate Director Job Eli Lilly - R&D Informatics Data Capability, Apply Now!
Lilly is hiring an Associate Director – R&D Informatics Data Capability to lead...
IISER Tirupati Research Associate Vacancy, PhD Cell Biology Candidates Can Apply!
IISER Tirupati Research Associate Vacancy, PhD Cell Biology Candidates Can Apply!
The Indian Institute of Science Education and Research (IISER) Tirupati, a premier autonomous institution...
Endo Microbiology Job: Apply for Analyst Position Now!
Analyst Microbiology Job at Endo | R&D Microbio job in Digha
Endo, a global pharmaceutical leader, is hiring a skilled Analyst in Microbiology for its...
Senior Microbiologist Job at Stryker! Apply Now!
Senior Microbiologist Job at Stryker | M.Sc. in Microbiology Apply Now
Looking to elevate your career in the medical technology industry? Stryker, a global leader...
Freshers CRISPR-based Genome Screening Project Recruitment at CSIR-IGIB, Apply Online
Freshers Project Jobs at CSIR-IGIB, Apply Online
Freshers CSIR-IGIB Vacancies - Project Job For Mol Bio, Comp Bio, Apply Online. Interested and eligible applicants can...
Junior Research Fellow at Prestigious Presidency University in Kolkata!
JRF Position at Presidency University, Kolkata| MSc Biotech Apply Now!
Presidency University, Kolkata, is inviting applications for a Junior Research Fellow (JRF) position at its...
Post-Doctoral Fellow at NISER Bhubaneswar – PhD Life Sciences Candidates Apply Now, Fellowship up...
Post-Doctoral Fellow at NISER Bhubaneswar - PhD Life Sciences Candidates Apply Now, Fellowship up to ₹67,000/month
The National Institute of Science Education and Research (NISER),...
BRIC-NIBMG PhD Program 2025 Admissions Open – Apply Online
BRIC-NIBMG PhD Program 2025 Admissions Open - Apply Online
Ref. No NIBMG/ADMIN/ESTB/PHD PROG/ADVT/2025-26/07 Date 04-04-2025
INFORMATION FOR STUDENTS INTERESTED TO PURSUE DOCTORAL RESEARCH AT THE BRIC-NATIONAL...
Machine Learning in Drug Discovery: Careers, Skills & Trends You Can’t Miss!
Machine Learning in Drug Discovery: Jobs, Skills, and Trends
Welcome to the new era of healthcare and medicine, where AI (Artificial Intelligence) and ML (Machine...
10+ Freshers & Experienced Vacancies at 30M Genomics – BSc, MSc & PhD Apply...
Freshers Vacancies at 30M Genomics - BSc, MSc & PhD Apply Online Only at Biotecnika
Company Name- 30M Genomics.
Job Title: Molecular Biologist.
CTC- 3.6 LPA -...
Biotecnika Times Newsletter 09.04.2025 – Freshers Jobs at Syngene, Vimta Labs, Britannia Industries Ltd,...
BioTecNika Info Labs Pvt Ltd | Established 2006 | For you
BioTecNika Times
ONLINE | BANGALORE
18 Years of Service dedicated to Bio Professionals & Biotech Industry
///////////////////////////////////////////////////////////////////////////////////////////////////////////////////////
All India Toll Free Ph:...
NISER PhD 2025-26 Admissions Open in School of Biological Sciences (Summer Session), Apply Online
NISER PhD 2025-26 Admissions Open in School of Biological Sciences (Summer Session), Apply Online
NATIONAL INSTITUTE OF SCIENCE EDUCATION AND RESEARCH
BHUBANESWAR
Advt.No: NISER / ACAD /...
Notification For AI & ML in Biology Summer Hands-On Training Program With Projects Work...
AI ML in Biology Summer Training
Do You Also Want to Ride the AI-ML Wave? Don’t get left behind as a biologist!AI and Machine Learning...
Senior Project Associate at NIBMG – Apply Now!
Senior Project Associate Job at NIBMG – M.Sc. Life Science Apply Now!
The National Institute of Biomedical Genomics (NIBMG) is inviting applications for the position...